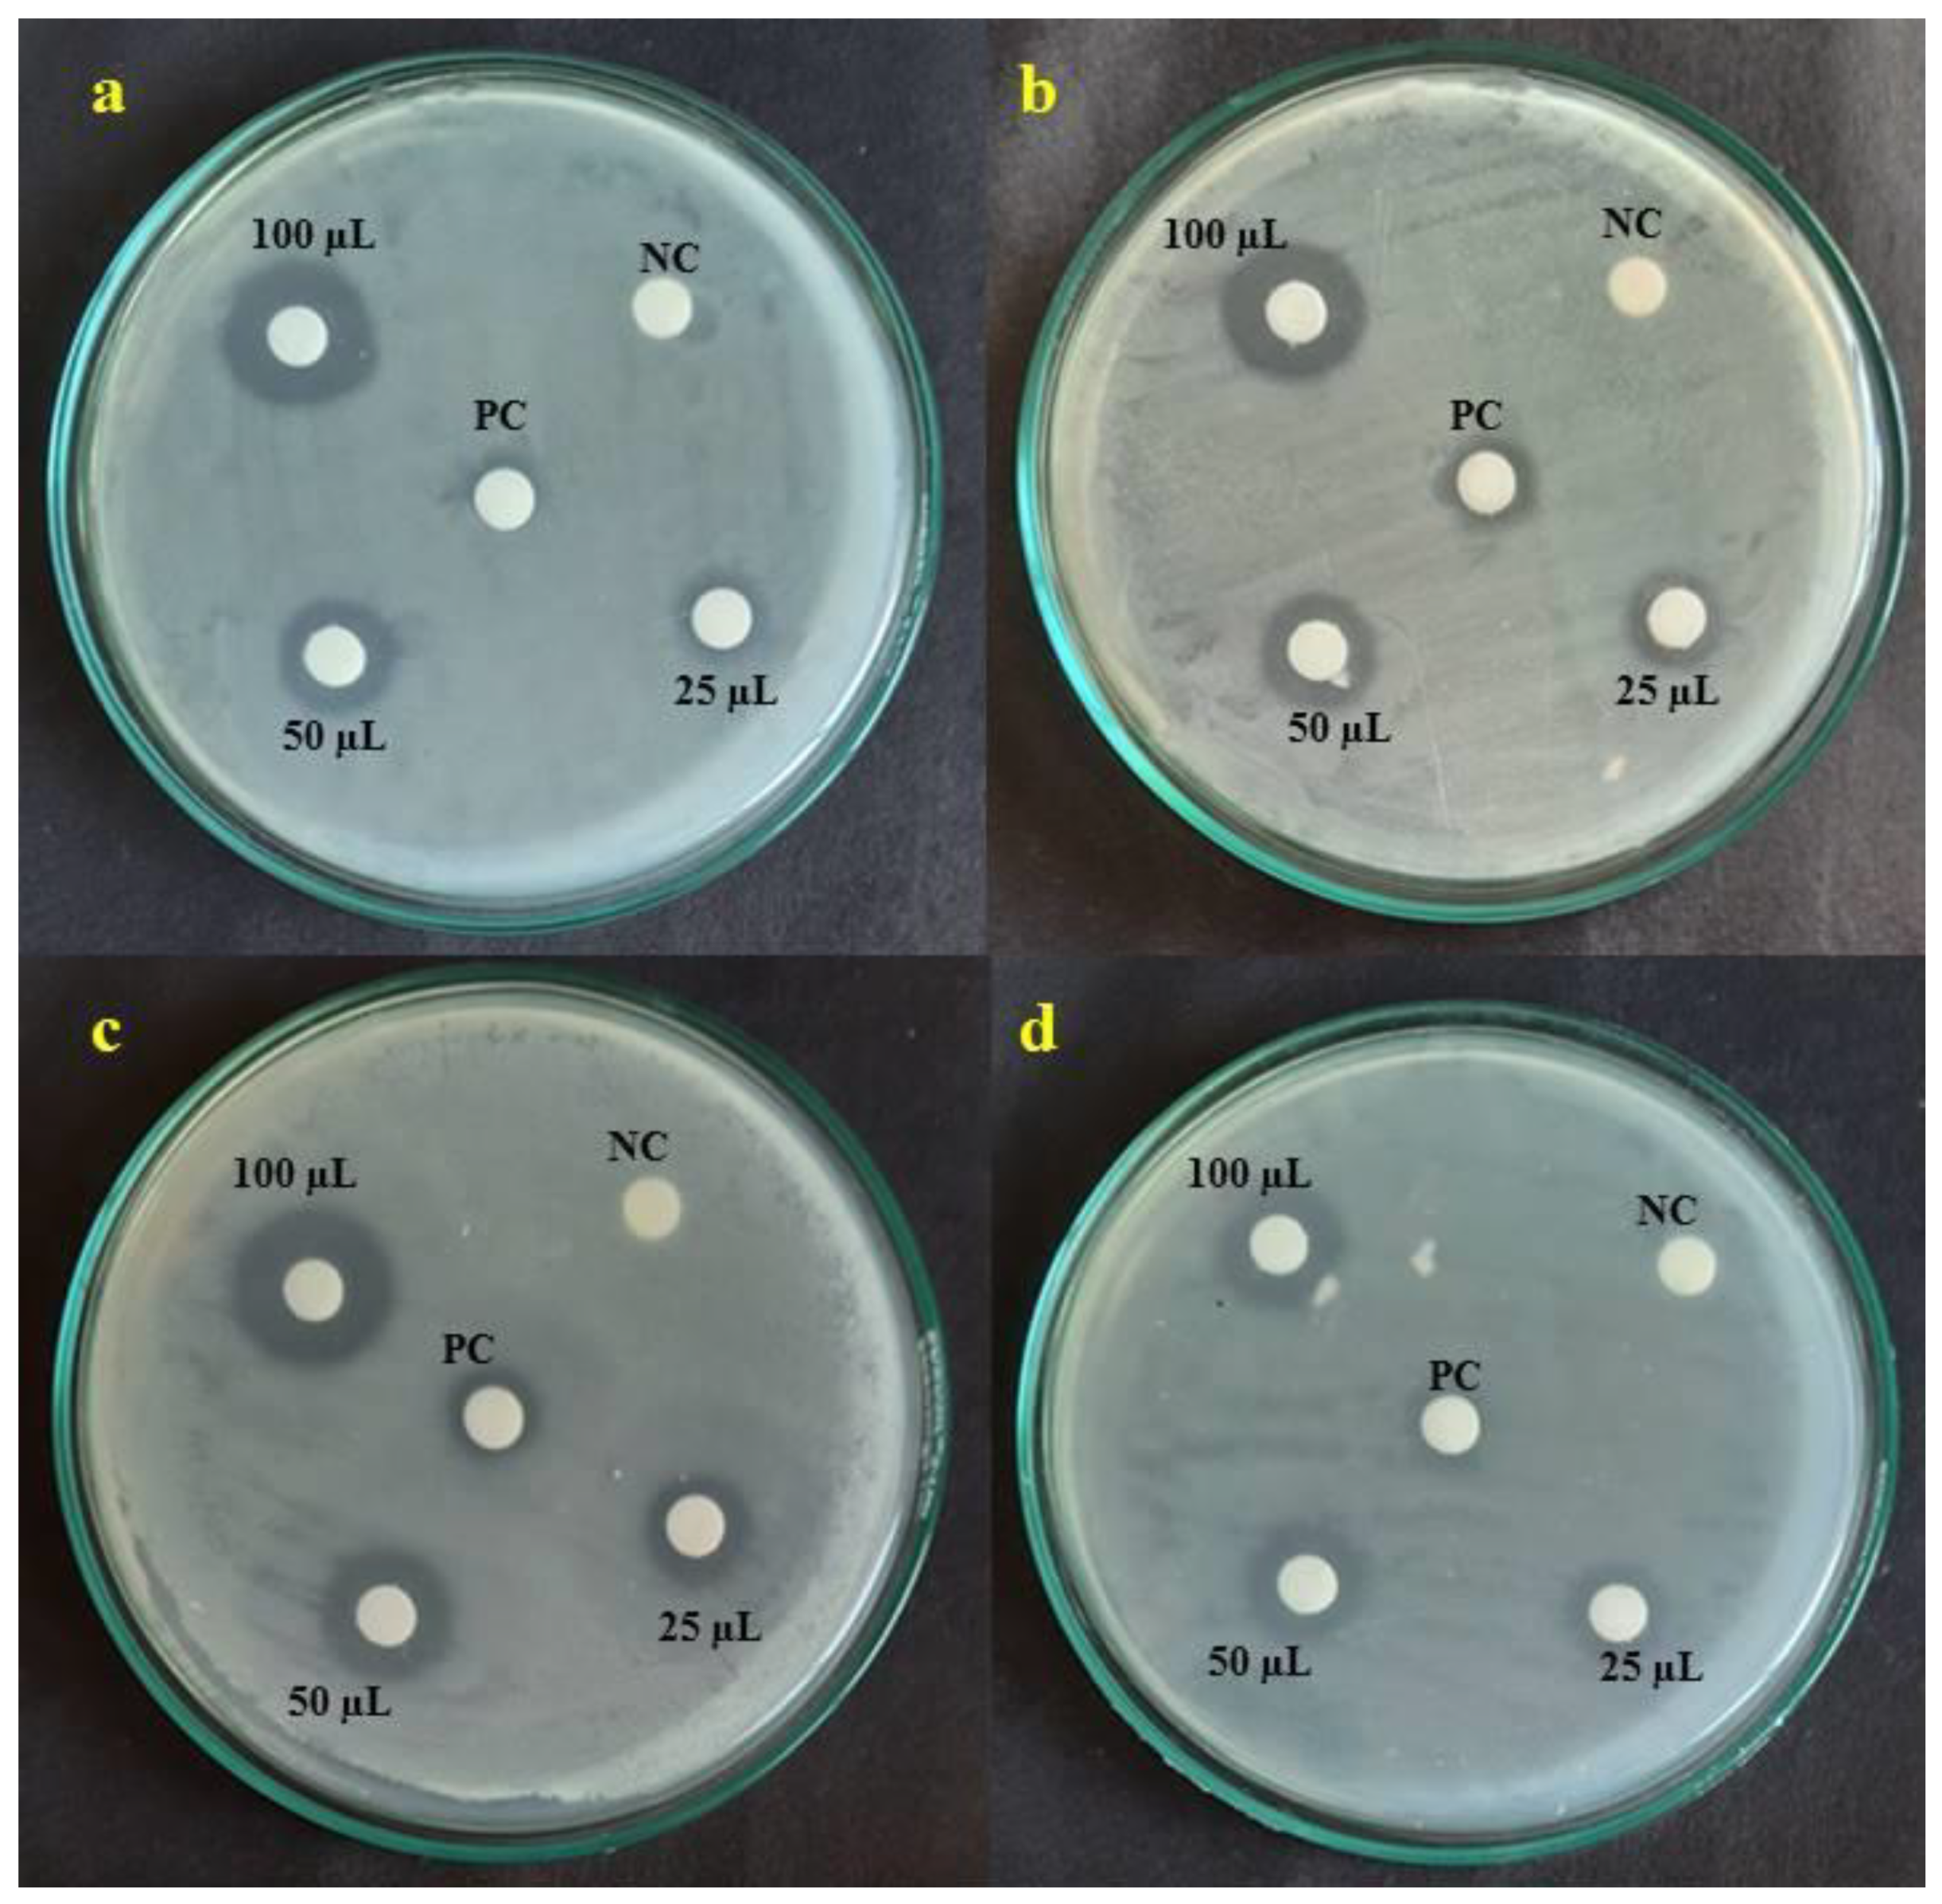
Crystals 12 00072 g008

Green Synthesis of Mn + Cu Bimetallic Nanoparticles Using Vinca rosea Extract and Their Antioxidant, Antibacterial, and Catalytic Activities
Abstract
:1. Introduction
2. Materials and Methods
2.1. Materials
2.2. Plant Collection and Extract Preparation
2.3. Synthesis of Vr-Mn + Cu NPs
2.4. Characterization of Vr-Mn + Cu NPs
2.5. DPPH Scavenging Activity
2.6. Hydrogen Peroxide Activity
2.7. Hydroxyl Radical Scavenging Activity
2.8. FRAP
2.9. Minimum Inhibitory Concentration (MIC)
2.10. Antibacterial Activity
2.11. Degradation of Dye using Vr-Mn + Cu NPs
2.12. Catalytic Efficiency in Reduction of 4-Nitrophenol
3. Result and Discussion
3.1. UV–Visible Spectrophotometer Analysis
3.2. FT–IR Analysis
3.3. XRD Analysis
3.4. SEM and EDX Analysis
3.5. DLS Analysis
4. Antioxidant Activity
4.1. DPPH
4.2. H2O2
4.3. Hydroxyl Radical Scavenging Activity
4.4. FRAP Assay
4.5. Minimum Inhibitory Concentration
4.6. Antimicrobial Susceptibility Testing
4.7. Photocatalytic Dye Degradation Activity
4.8. Catalytic Efficiency
5. Conclusions
Author Contributions
Funding
Institutional Review Board Statement
Informed Consent Statement
Data Availability Statement
Acknowledgments
Conflicts of Interest
References
- Rayman, M.P. Selenium in cancer prevention: A review of the evidence and mechanism of action. Proc. Nutr. Soc. 2005, 64, 527–542. [Google Scholar] [CrossRef] [Green Version]
- Watlington, K. Emerging Nanotechnologies for Site Remediation and Wastewater Treatment; Environmental Protection Agency: Washington, DC, USA, 2005.
- Ferrari, M. Cancer nanotechnology: Opportunities and challenges. Nat. Rev. Cancer 2005, 5, 161–171. [Google Scholar] [CrossRef]
- Khan, M.S.; Kim, H.; Kim, Y.; Ebina, Y.; Sugimoto, W.; Sasaki, T.; Osada, M. Scalable Design of Two-Dimensional Oxide Nanosheets for Construction of Ultrathin Multilayer Nanocapacitor. Small 2020, 16, 2003485. [Google Scholar] [CrossRef] [PubMed]
- Khan, M.S.; Osada, M.; Kim, H.-J.; Ebina, Y.; Sugimoto, W.; Sasaki, T. High-temperature dielectric responses in all-nanosheet capacitors. Jpn. J. Appl. Phys. 2017, 56, 06GH09. [Google Scholar] [CrossRef]
- Waqas Alam, M.; Khatoon, U.; Qurashi, A. Synthesis and characterization of Cu-SnO2 nanoparticles deposited on glass using ultrasonic spray pyrolysis and their H2S sensing properties. Curr. Nanosci. 2012, 8, 919–924. [Google Scholar] [CrossRef]
- Banach, M.; Pulit-Prociak, J. Proecological method for the preparation of metal nanoparticles. J. Clean. Prod. 2017, 141, 1030–1039. [Google Scholar] [CrossRef]
- Devanesan, S.; AlSalhi, M.S.; Vishnubalaji, R.; Alfuraydi, A.A.; Alajez, N.M.; Alfayez, M.; Murugan, K.; Sayed, S.R.M.; Nicoletti, M.; Benelli, G. Rapid biological synthesis of silver nanoparticles using plant seed extracts and their cytotoxicity on colorectal cancer cell lines. J. Clust. Sci. 2017, 28, 595–605. [Google Scholar] [CrossRef]
- Rajagopal, G.; Nivetha, A.; Sundar, M.; Panneerselvam, T.; Murugesan, S.; Parasuraman, P.; Kumar, S.; Ilango, S.; Kunjiappan, S. Mixed phytochemicals mediated synthesis of copper nanoparticles for anticancer and larvicidal applications. Heliyon 2021, 7, e07360. [Google Scholar] [CrossRef] [PubMed]
- Burda, C.; Chen, X.; Narayanan, R.; El-Sayed, M.A. Chemistry and properties of nanocrystals of different shapes. Chem. Rev. 2005, 105, 1025–1102. [Google Scholar] [CrossRef]
- Ferrando, R.; Jellinek, J.; Johnston, R.L. Nanoalloys: From theory to applications of alloy clusters and nanoparticles. Chem. Rev. 2008, 108, 845–910. [Google Scholar] [CrossRef]
- Rodriguez, J.A.; Goodman, D.W. The nature of the metal-metal bond in bimetallic surfaces. Science 1992, 257, 897–903. [Google Scholar] [CrossRef]
- Tao, F.; Grass, M.E.; Zhang, Y.; Butcher, D.R.; Renzas, J.R.; Liu, Z.; Chung, J.Y.; Mun, B.S.; Salmeron, M.; Somorjai, G.A. Reaction-driven restructuring of Rh-Pd and Pt-Pd core-shell nanoparticles. Science 2008, 322, 932–934. [Google Scholar] [CrossRef] [Green Version]
- Rajagopal, G.; Manivannan, N.; Sundararajan, M.; Kumar, A.G.; Samuthirarajan, S.; Mathivanan, N.; Ilango, S. Biocompatibility assessment of silver chloride nanoparticles derived from Padina gymnospora and its therapeutic potential. Nano Express 2021, 2, 010010. [Google Scholar] [CrossRef]
- Gupta, R.; Xie, H. Nanoparticles in daily life: Applications, toxicity and regulations. J. Environ. Pathol. Toxicol. Oncol. 2018, 37, 209–230. [Google Scholar] [CrossRef]
- Hua, S.; de Matos, M.B.C.; Metselaar, J.M.; Storm, G. Current trends and challenges in the clinical translation of nanoparticulate nanomedicines: Pathways for translational development and commercialization. Front. Pharmacol. 2018, 9, 790. [Google Scholar] [CrossRef] [PubMed]
- Elechiguerra, J.L.; Burt, J.L.; Morones, J.R.; Camacho-Bragado, A.; Gao, X.; Lara, H.H.; Yacaman, M.J. Interaction of silver nanoparticles with HIV-1. J. Nanobiotechnol. 2005, 3, 6. [Google Scholar] [CrossRef] [Green Version]
- Khan, M.; Al-Marri, A.H.; Khan, M.; Shaik, M.R.; Mohri, N.; Adil, S.F.; Kuniyil, M.; Alkhathlan, H.Z.; Al-Warthan, A.; Tremel, W. Green approach for the effective reduction of graphene oxide using Salvadora persica L. root (Miswak) extract. Nanoscale Res. Lett. 2015, 10, 281. [Google Scholar] [CrossRef] [PubMed] [Green Version]
- He, Y. Synthesis of ZnO nanoparticles with narrow size distribution under pulsed microwave heating. China Particuology 2004, 2, 168–170. [Google Scholar] [CrossRef]
- Chun, H.; Yizhong, W. Decolorization and biodegradability of photocatalytic treated azo dyes and wool textile wastewater. Chemosphere 1999, 39, 2107–2115. [Google Scholar] [CrossRef]
- Kiwi, J.; Pulgarin, C.; Peringer, P.; Grätzel, M. Beneficial effects of homogeneous photo-Fenton pretreatment upon the biodegradation of anthraquinone sulfonate in waste water treatment. Appl. Catal. B Environ. 1993, 3, 85–99. [Google Scholar] [CrossRef]
- Li, J.; Xu, Y.; Liu, Y.; Wu, D.; Sun, Y. Synthesis of hydrophilic ZnS nanocrystals and their application in photocatalytic degradation of dye pollutants. China Particuol. 2004, 2, 266–269. [Google Scholar] [CrossRef]
- Hoffmann, M.R.; Martin, S.T.; Choi, W.; Bahnemann, D.W. Environmental applications of semiconductor photocatalysis. Chem. Rev. 1995, 95, 69–96. [Google Scholar] [CrossRef]
- Basharat, M.; Khan, M.S.; Abbas, Y.; Zhang, S.; Ma, H.; Wu, Z.; Liu, W. Cyclotriphosphazene (P3N3) hybrid framework for aggregation induced photocatalytic hydrogen evolution and degradation of rhodamine B. Mater. Chem. Front. 2020, 4, 3216–3225. [Google Scholar] [CrossRef]
- Irfan, M.F.; Qurashi, A.; Alam, M.W. Metal oxide nanostructures and nanocomposites for selective catalytic reduction of NOx: A review. Arab. J. Sci. Eng. 2010, 35, 79–92. [Google Scholar]
- Aarthi, T.; Narahari, P.; Madras, G. Photocatalytic degradation of Azure and Sudan dyes using nano TiO2. J. Hazard. Mater. 2007, 149, 725–734. [Google Scholar] [CrossRef] [PubMed]
- Matthews, R.W. Kinetics of photocatalytic oxidation of organic solutes over titanium dioxide. J. Catal. 1988, 111, 264–272. [Google Scholar] [CrossRef]
- Dahl, J.A.; Maddux, B.L.S.; Hutchison, J.E. Toward greener nanosynthesis. Chem. Rev. 2007, 107, 2228–2269. [Google Scholar] [CrossRef] [Green Version]
- Valsalam, S.; Agastian, P.; Esmail, G.A.; Ghilan, A.-K.M.; Al-Dhabi, N.A.; Arasu, M.V. Biosynthesis of silver and gold nanoparticles using Musa acuminata colla flower and its pharmaceutical activity against bacteria and anticancer efficacy. J. Photochem. Photobiol. B Biol. 2019, 201, 111670. [Google Scholar] [CrossRef]
- Sowndarya, P.; Ramkumar, G.; Shivakumar, M.S. Green synthesis of selenium nanoparticles conjugated Clausena dentata plant leaf extract and their insecticidal potential against mosquito vectors. Artif. Cells Nanomed. Biotechnol. 2017, 45, 1490–1495. [Google Scholar] [CrossRef] [Green Version]
- Jaleel, C.A.; Gopi, R.; Lakshmanan, G.M.A.; Panneerselvam, R. Triadimefon induced changes in the antioxidant metabolism and ajmalicine production in Catharanthus roseus (L.) G. Don. Plant Sci. 2006, 171, 271–276. [Google Scholar] [CrossRef]
- Jordan, M.A.; Thrower, D.; Wilson, L. Mechanism of inhibition of cell proliferation by Vinca alkaloids. Cancer Res. 1991, 51, 2212–2222. [Google Scholar]
- Kulkarni, R.N.; Baskaran, K.; Chandrashekara, R.S.; Kumar, S. Inheritance of morphological traits of periwinkle mutants with modified contents and yields of leaf and root alkaloids. Plant Breed. 1999, 118, 71–74. [Google Scholar] [CrossRef]
- Ahmed, M.F.; Kazim, S.M.; Ghori, S.S.; Mehjabeen, S.S.; Ahmed, S.R.; Ali, S.M.; Ibrahim, M. Antidiabetic activity of Vinca rosea extracts in alloxan-induced diabetic rats. Int. J. Endocrinol. 2010, 2010, 841090. [Google Scholar] [CrossRef]
- Gülçin, İ. Antioxidant activity of eugenol: A structure–activity relationship study. J. Med. Food 2011, 14, 975–985. [Google Scholar] [CrossRef]
- Cetinkaya, Y.; Göçer, H.; Menzek, A.; Gülçin, İ. Synthesis and antioxidant properties of (3, 4-dihydroxyphenyl)(2,3,4-trihydroxyphenyl) methanone and its derivatives. Arch. Pharm. 2012, 345, 323–334. [Google Scholar] [CrossRef]
- Halliwell, B.; Gutteridge, J.M.C. Formation of a thiobarbituric-acid-reactive substance from deoxyribose in the presence of iron salts: The role of superoxide and hydroxyl radicals. FEBS Lett. 1981, 128, 347–352. [Google Scholar] [CrossRef] [Green Version]
- Benzie, I.F.F.; Strain, J.J. The ferric reducing ability of plasma (FRAP) as a measure of “antioxidant power”: The FRAP assay. Anal. Biochem. 1996, 239, 70–76. [Google Scholar] [CrossRef] [Green Version]
- Zhu, Q.Y.; Holt, R.R.; Lazarus, S.A.; Orozco, T.J. Inhibitory effects of cocoa flavanols and procyanidin oligomers on free radical-induced erythrocyte hemolysis. Exp. Biol. Med. 2002, 227, 321–329. [Google Scholar] [CrossRef] [PubMed]
- Garibo, D.; Borbón-Nuñez, H.A.; de León, J.N.D.; Mendoza, E.G.; Estrada, I.; Toledano-Magaña, Y.; Tiznado, H.; Ovalle-Marroquin, M.; Soto-Ramos, A.G.; Blanco, A. Green synthesis of silver nanoparticles using Lysiloma acapulcensis exhibit high-antimicrobial activity. Sci. Rep. 2020, 10, 12805. [Google Scholar] [CrossRef] [PubMed]
- Jayaraj, A.J.; Uchimahali, J.; Gnanasundaram, T.; Thirumal, S. Evaluation of antimicrobial activity and phytochemicals analysis of whole plant extract of Vinca rosea. Evaluation 2019, 12, 132–136. [Google Scholar]
- Rafique, M.; Shaikh, A.J.; Rasheed, R.; Tahir, M.B.; Gillani, S.S.A.; Usman, A.; Imran, M.; Zakir, A.; Khan, Z.U.H.; Rabbani, F. Aquatic biodegradation of methylene blue by copper oxide nanoparticles synthesized from Azadirachta indica leaves extract. J. Inorg. Organomet. Polym. Mater. 2018, 28, 2455–2462. [Google Scholar] [CrossRef]
- Dehvari, K.; Li, J.-D.; Chang, J.-Y. Bovine serum albumin-templated synthesis of manganese-doped copper selenide nanoparticles for boosting targeted delivery and synergistic photothermal and photodynamic therapy. ACS Appl. Bio Mater. 2019, 2, 3019–3029. [Google Scholar] [CrossRef]
- Hemalatha, C.; Babu, K.S.; Rao, G.N. Mn Doped CuO Nanoparticles Synthesized by Spray Pyrolysis: Structural, Optical and Magnetic Characterization. J. Magn. 2020, 25, 330–334. [Google Scholar] [CrossRef]
- Nasrollahzadeh, M.; Sajjadi, M.; Sajadi, S.M. Biosynthesis of copper nanoparticles supported on manganese dioxide nanoparticles using Centella asiatica L. leaf extract for the efficient catalytic reduction of organic dyes and nitroarenes. Chin. J. Catal. 2018, 39, 109–117. [Google Scholar] [CrossRef]
- Alsaheb, M.A.; Alsahib, S.A. Synthesis, Characterization and polymerization of 1Hpyrazolo [1,2-b] phthalazine-5, 10-dione derivatives Using CuO nanoparticle Oxide from Natural Source as Catalyst. Drug Deliv. 2020, 10, 530–536. [Google Scholar]
- Clogston, J.D.; Patri, A.K. Zeta potential measurement. In Characterization of Nanoparticles Intended for Drug Delivery; Springer: Cham, Switzerland, 2011; pp. 63–70. [Google Scholar]
- Agarwal, P.; Gupta, R.; Agarwal, N. Advances in synthesis and applications of microalgal nanoparticles for wastewater treatment. J. Nanotechnol. 2019, 2019, 7392713. [Google Scholar] [CrossRef] [Green Version]
- Devatha, C.P.; Jagadeesh, K.; Patil, M. Effect of Green synthesized iron nanoparticles by Azardirachta Indica in different proportions on antibacterial activity. Environ. Nanotechnol. Monit. Manag. 2018, 9, 85–94. [Google Scholar] [CrossRef]
- Sundar, M.; Suresh, S.; Lingakumar, K. Influence of Caralluma adscendens Var. attenuata cold cream on UV-B damaged skin epidermal cells: A novel approach. 3 Biotech 2021, 11, 155. [Google Scholar] [CrossRef]
- Satheeshkumar, M.K.; Kumar, E.R.; Indhumathi, P.; Srinivas, C.; Deepty, M.; Sathiyaraj, S.; Suriyanarayanan, N.; Sastry, D.L. Structural, morphological and magnetic properties of algae/CoFe2O4 and algae/Ag-Fe-O nanocomposites and their biomedical applications. Inorg. Chem. Commun. 2020, 111, 107578. [Google Scholar] [CrossRef]
- Korycka-Dahl, M.; Richardson, T. Photogeneration of superoxide anion in serum of bovine milk and in model systems containing riboflavin and amino acids. J. Dairy Sci. 1978, 61, 400–407. [Google Scholar] [CrossRef]
- Yang, H.; Yang, R.; Zhang, P.; Qin, Y.; Chen, T.; Ye, F. A bimetallic (Co/2Fe) metal-organic framework with oxidase and peroxidase mimicking activity for colorimetric detection of hydrogen peroxide. Microchim. Acta 2017, 184, 4629–4635. [Google Scholar] [CrossRef]
- Zhou, Y.; Zhang, Y.; Hu, X. Novel zero-valent Co–Fe encapsulated in nitrogen-doped porous carbon nanocomposites derived from CoFe2O4@ ZIF-67 for boosting 4-chlorophenol removal via coupling peroxymonosulfate. J. Colloid Interface Sci. 2020, 575, 206–219. [Google Scholar] [CrossRef]
- Shimada, K.; Fujikawa, K.; Yahara, K.; Nakamura, T. Antioxidative properties of xanthan on the autoxidation of soybean oil in cyclodextrin emulsion. J. Agric. Food Chem. 1992, 40, 945–948. [Google Scholar] [CrossRef]
- Abalkhil, T.A.; Alharbi, S.A.; Salmen, S.H.; Wainwright, M. Bactericidal activity of biosynthesized silver nanoparticles against human pathogenic bacteria. Biotechnol. Biotechnol. Equip. 2017, 31, 411–417. [Google Scholar] [CrossRef] [Green Version]
- Song, H.Y.; Ko, K.K.; Oh, L.H.; Lee, B.T. Fabrication of silver nanoparticles and their antimicrobial mechanisms. Eur. Cells Mater. 2006, 11, 58. [Google Scholar]
- Panáček, A.; Kvitek, L.; Prucek, R.; Kolář, M.; Večeřová, R.; Pizúrová, N.; Sharma, V.K.; Nevěčná, T.J.; Zbořil, R. Silver colloid nanoparticles: Synthesis, characterization, and their antibacterial activity. J. Phys. Chem. B 2006, 110, 16248–16253. [Google Scholar] [CrossRef]
- Zou, Y.-H.; Wang, J.; Cui, L.-Y.; Zeng, R.-C.; Wang, Q.-Z.; Han, Q.-X.; Qiu, J.; Chen, X.-B.; Chen, D.-C.; Guan, S.-K.; et al. Corrosion resistance and antibacterial activity of zinc-loaded montmorillonite coatings on biodegradable magnesium alloy AZ31. Acta Biomater. 2019, 98, 196–214. [Google Scholar] [CrossRef]
- Senthilraja, A.; Krishnakumar, B.; Hariharan, R.; Sobral, A.J.F.; Surya, C.; Agnel Arul John, N.; Shanthi, M. Synthesis and characterization of bimetallic nanocomposite and its photocatalytic, antifungal and antibacterial activity. Sep. Purif. Technol. 2018, 202, 373–384. [Google Scholar] [CrossRef]
- Dhillon, G.S.; Kaur, S.; Brar, S.K. Facile fabrication and characterization of chitosan-based zinc oxide nanoparticles and evaluation of their antimicrobial and antibiofilm activity. Int. Nano Lett. 2014, 4, 107. [Google Scholar] [CrossRef] [Green Version]
- Zhao, X.; Jia, Y.; Dong, R.; Deng, J.; Tang, H.; Hu, F.; Liu, S.; Jiang, X. Bimetallic nanoparticles against multi-drug resistant bacteria. Chem. Commun. 2020, 56, 10918–10921. [Google Scholar] [CrossRef]
- Jayarambabu, N.; Akshaykranth, A.; Rao, T.V.; Rao, K.V.; Kumar, R.R. Green synthesis of Cu nanoparticles using Curcuma longa extract and their application in antimicrobial activity. Mater. Lett. 2020, 259, 126813. [Google Scholar] [CrossRef]
- Patra, S.; Roy, E.; Madhuri, R.; Sharma, P.K. Agar based bimetallic nanoparticles as high-performance renewable adsorbent for removal and degradation of cationic organic dyes. J. Ind. Eng. Chem. 2016, 33, 226–238. [Google Scholar] [CrossRef]

| Minimum Inhibitory Concentration (MIC) (mg/mL) | |||||||
|---|---|---|---|---|---|---|---|
| E. coli | K. pneumonia | S. typhi | S. aureus | ||||
| PC | NP | PC | NP | PC | NP | PC | NP |
| 0.1 | 0.32 | 0.1 | 0.64 | 0.2 | 0.64 | 0.2 | 0.64 |
| Bacteria | Zone of Inhibition (mm) | |||
|---|---|---|---|---|
| Standard | 25 µL | 50 µL | 100 µL | |
| E. coli | 7.33 ± 0.57 | 9.00 ± 1.00 | 11.33 ± 0.57 | 16.33 ± 0.57 |
| K. pneumonia | 8.67 ± 0.57 | 7.33 ± 0.57 | 10.67 ± 0.57 | 14.67 ± 1.57 |
| S. typhi | 10.7 ± 0.57 | 9.33 ± 0.57 | 11.33 ± 0.57 | 15.33 ± 0.57 |
| S. aureus | 9.00 ± 0.00 | 11.00 ± 1.00 | 12.66 ± 0.57 | 14.33 ± 0.57 |
Publisher’s Note: MDPI stays neutral with regard to jurisdictional claims in published maps and institutional affiliations. |
© 2022 by the authors. Licensee MDPI, Basel, Switzerland. This article is an open access article distributed under the terms and conditions of the Creative Commons Attribution (CC BY) license (https://creativecommons.org/licenses/by/4.0/).
Share and Cite
Ahmad, M.M.; Kotb, H.M.; Mushtaq, S.; Waheed-Ur-Rehman, M.; Maghanga, C.M.; Alam, M.W. Green Synthesis of Mn + Cu Bimetallic Nanoparticles Using Vinca rosea Extract and Their Antioxidant, Antibacterial, and Catalytic Activities. Crystals 2022, 12, 72. https://doi.org/10.3390/cryst12010072
Ahmad MM, Kotb HM, Mushtaq S, Waheed-Ur-Rehman M, Maghanga CM, Alam MW. Green Synthesis of Mn + Cu Bimetallic Nanoparticles Using Vinca rosea Extract and Their Antioxidant, Antibacterial, and Catalytic Activities. Crystals. 2022; 12(1):72. https://doi.org/10.3390/cryst12010072
Chicago/Turabian StyleAhmad, Mohamad M., Hicham Mahfoz Kotb, Shehla Mushtaq, Mir Waheed-Ur-Rehman, Christopher M. Maghanga, and Mir Waqas Alam. 2022. "Green Synthesis of Mn + Cu Bimetallic Nanoparticles Using Vinca rosea Extract and Their Antioxidant, Antibacterial, and Catalytic Activities" Crystals 12, no. 1: 72. https://doi.org/10.3390/cryst12010072
APA StyleAhmad, M. M., Kotb, H. M., Mushtaq, S., Waheed-Ur-Rehman, M., Maghanga, C. M., & Alam, M. W. (2022). Green Synthesis of Mn + Cu Bimetallic Nanoparticles Using Vinca rosea Extract and Their Antioxidant, Antibacterial, and Catalytic Activities. Crystals, 12(1), 72. https://doi.org/10.3390/cryst12010072

